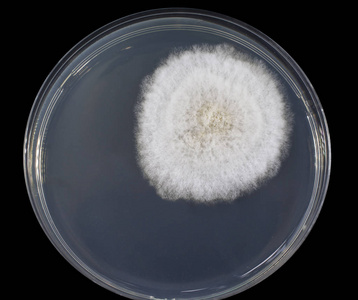
真菌菌落图片-真菌菌落素材-真菌菌落插画-摄图新视界
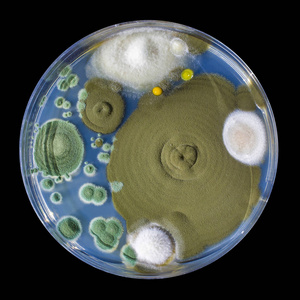
真菌菌落图片-真菌菌落素材-真菌菌落插画-摄图新视界

真菌菌落

大讲堂真菌图片小札(一) - 美篇
图片尺寸1200x1200
绿色的真菌菌落在黑色的琼脂平板上分离出来
图片尺寸1116x1100
大讲堂真菌图片小札(一) - 美篇
图片尺寸720x1280
有图,帮助鉴定菌落 - 食品微生物检测 - 食品论坛 - powered by discu
图片尺寸3456x2592
真菌为什么难以杀灭,有什么消毒液可以做到
图片尺寸800x551
在琼脂平板上分离出不同的真菌菌落
图片尺寸1103x1100
大讲堂真菌图片小札(一) - 美篇
图片尺寸600x800
大讲堂真菌图片小札(一) - 美篇
图片尺寸1200x1200
大讲堂真菌图片小札(一) - 美篇
图片尺寸1080x923
11-真菌08ppt_word文档在线阅读与下载_免费文档
图片尺寸1080x810
真菌菌落图片-真菌菌落素材-真菌菌落插画-摄图新视界
图片尺寸358x300
霉菌图片-霉菌素材-霉菌插画-摄图新视界
图片尺寸449x300
真菌菌落图片-真菌菌落素材-真菌菌落插画-摄图新视界
图片尺寸300x300
建阳桔柚两种真菌病原菌的鉴定
图片尺寸700x371
环境工程微生物技术-日职网络教学平台
图片尺寸558x238
真菌和细菌菌落在黑色琼脂平板上分离
图片尺寸1144x1100
真菌菌落分离于黑色琼脂平板上
图片尺寸1119x1100
真菌菌落图片-真菌菌落素材-真菌菌落插画-摄图新视界
图片尺寸323x300
【分享】scedosporium apiospermum 尖端赛多孢子菌-茉莉花
图片尺寸2592x1944
立体显微镜下的真菌菌落
图片尺寸1200x800